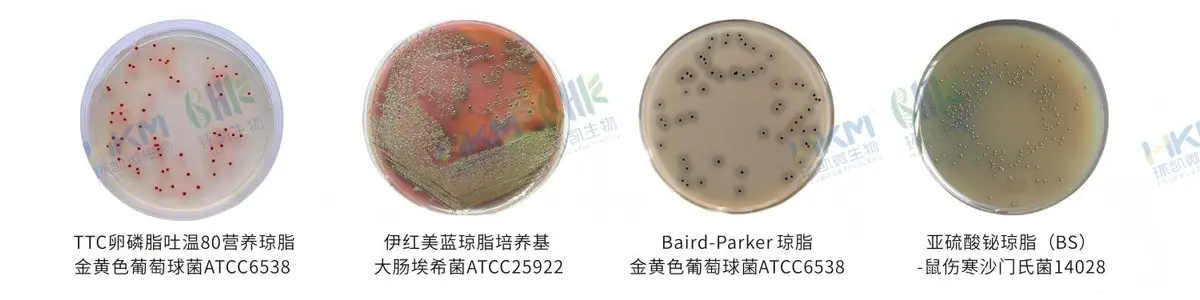
化妆品安全技术规范系列产品
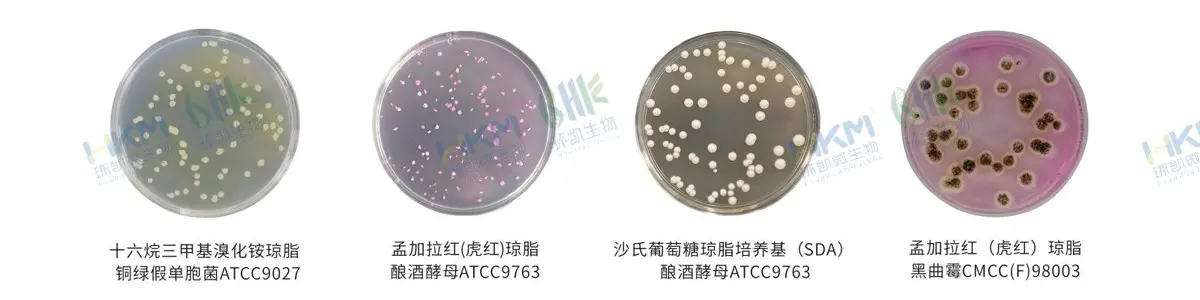
化妆品防腐挑战测试系列产品
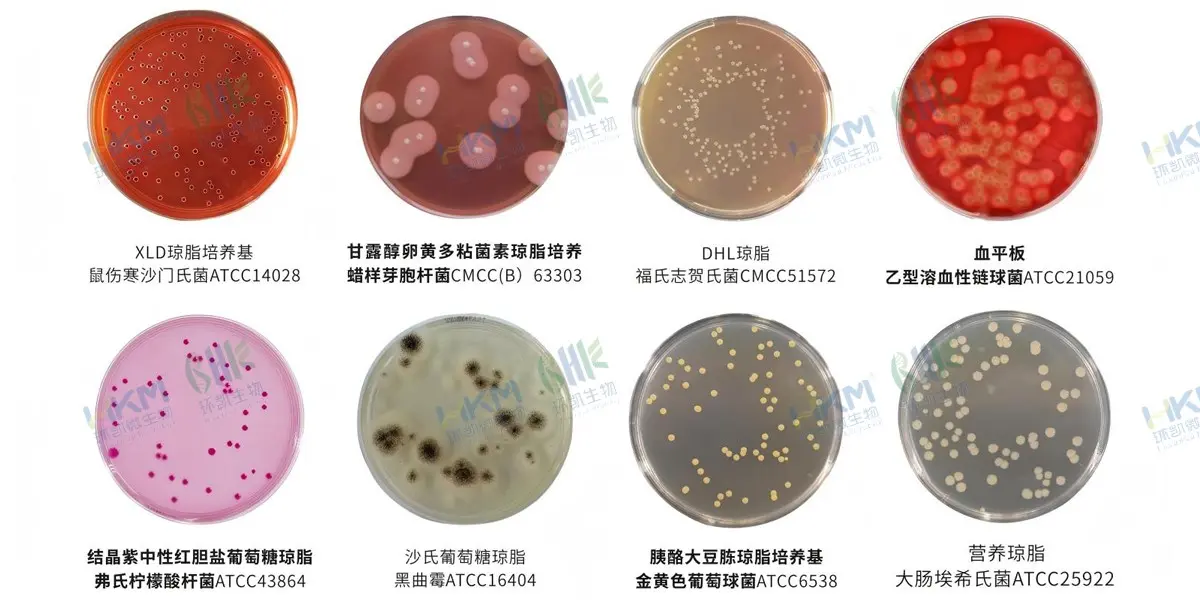
SN/T2206化妆品微生物检验系列产品

商品详细
说明书
微生物图册
行业应用
相关论文
环凯微生物自1993年开始研发生产销售微生物检测与控制相关产品,依托广东省微生物研究所及其自身优势,建有多条业内先进的生产线和现代化高标准研发、质控实验室,拥有经验丰富的技术团队,并已通过ISO9001质量体系认证,成为国内培养基行业的核心品牌。
化妆品中含有丰富的营养物质、水分、适宜pH值,是微生物生长的良好“培养基”。而在化妆品生产过程中,微生物污染通常来源于原料带入,产品制备和灌装过程等各环节,因此,从源头和生产过程对污染微生物进行监控,采取相应的预防和控制措施,对于保证产品质量是非常必要的。环凯公司顺应化妆品行业对微生物监控发展趋势,推出化妆品微生物污染控制的成套产品解决方案,应用范围涵盖微生物检验(包括如包括菌落总数检验、粪大肠菌检验、金黄色葡萄球菌检验、铜绿假单胞菌检验、霉菌和酵母检验等)、生产环境卫生监控、防腐性能测试等方面,为化妆品行业健康快速发展保驾护航!
| 一、化妆品安全技术规范系列产品
| 1.1 菌落总数 | ||||
| 试验 | 货号 | 产品名称 | 产品规格 | 用途 |
| 样品稀释 | 027010 | SCDLP液体培养基 | 250g/瓶 | 用于疏水性化妆品样品处理及化妆品和一次性使用卫生用品增菌培养。 |
| 平板计数 | 027020 | 卵磷脂-吐温80营养琼脂 | 250g/瓶 | 用于化妆品细菌总数测定。 |
| 029226 | 0.5%无菌TTC溶液 | 2mL×10支/盒 | 每支添加于200ml(027020)中配成TTC卵磷脂-吐温80营养琼脂。 | |
| 027023 | 改良卵磷脂琼脂培养基 | 250g/瓶 | 用于化妆品中细菌总数计数。 | |
| 1.2 耐热大肠菌群检验 | ||||
| 试验 | 货号 | 产品名称 | 产品规格 | 用途 |
| 乳糖发酵 | 022043 | 双倍乳糖胆盐(含中和剂)培养基 | 250g/瓶 | 用于化妆品中粪大肠菌群的测定。 |
| C22043G1 | 双倍乳糖胆盐(含中和剂)培养基 | 10mL×20支/盒 | ||
| 分离确证 | 022060 | 卵磷脂-吐温80营养琼脂 | 250g/瓶 | 用于化妆品细菌总数测定。 |
| 024087 | 0.5%无菌TTC溶液 | 2mL×10支/盒 | 每支添加于200ml(027020)中配成TTC卵磷脂-吐温80营养琼脂。 | |
| 镜检 | 029010 | 革兰氏染色液 | 10mL×4瓶/盒 | 染色镜检。 |
| 靛基质试验 | 022110 | 蛋白胨水 | 100g/瓶 | 022110/075240蛋白胨水与029030配套使用,用于靛基质生化试验。 |
| 075240 | 蛋白胨水 | 20支(西林瓶)/盒 | ||
| 029030 | 靛基质试剂 | 10mL/瓶 | ||
| 1.3 金黄色葡萄球菌检验 | ||||
| 试验 | 货号 | 产品名称 | 产品规格 | 用途 |
| 增菌 | 027010 | SCDLP液体培养基 | 250g/瓶 | 用于疏水性化妆品样品处理及化妆品和一次性使用卫生用品增菌培养。 |
| CP7010P2 | SCDLP液体培养基 | 90mL×40瓶 | ||
| 平板分离 | 024040A | Baird-Parker琼脂平板 | 90mm×20个/盒 | 用于金黄色葡萄球菌的选择性分离培养。Baird-Parker琼脂基础(024040)临用前每95mL需添加1支配套试剂(029195) |
| 024040 | Baird-Parker琼脂基础 | 250g/瓶 | ||
| 029195 | 亚碲酸钾卵黄增菌剂 | 5mL×5支/盒 | ||
| 024070 | 血(琼脂)平板 | 90mm×20个/盒 | ||
| 镜检 | 029010 | 革兰氏染色液 | 10mL×4瓶/盒 | 染色镜检。 |
| 甘露醇发酵 | 024030 | 甘露醇发酵培养基 | 250g/瓶 | 用于金黄色葡萄球菌甘露醇发酵。 |
| 075040 | 甘露醇(生化管) | 20支(西林瓶)/盒 | ||
| 制备肉汤培养物 | 022010 | 营养肉汤 | 250g/瓶 | 用于金黄色葡萄球菌血浆凝固酶试验。 |
| 022012 | 营养肉汤 | 10mL/支×20支/盒 | ||
| 血浆凝固酶试验 | 029180 | 冻干血浆 | 10支/盒 | |
| 1.4 铜绿假单胞菌检验 | ||||
| 试验 | 货号 | 产品名称 | 产品规格 | 用途 |
| 增菌 | 027010 | SCDLP液体培养基 | 250g/瓶 | 用于疏水性化妆品样品处理及化妆品和一次性使用卫生用品中细菌的增菌培养。 |
| CP7010P2 | SCDLP液体培养基 | 90mL/瓶×40瓶 | ||
| 平板分离 | 027040 | 十六烷三甲基溴化铵琼脂 | 100g/瓶 | 铜绿假单胞菌的选择性分离培养。 |
| 024045A | 十六烷三甲基溴化铵琼脂平板 | 90mm×20个/盒 | ||
| 镜检 | 029010 | 革兰氏染色液 | 10mL×4瓶/盒 | 染色镜检。 |
| 生化确证 | 071840 | 绿脓杆菌生化鉴定盒 | 5种×10次/盒 | 用于氧化酶试验、绿脓菌素试验、硝酸盐还原产气试验、明胶液化试验、42C生长试验。 |
| 1.5 霉菌和酵母计数 | ||||
| 试验 | 货号 | 产品名称 | 产品规格 | 用途 |
| 平板计数 | 021010 | 孟加拉红(虎红)琼脂 | 250g/瓶 | 供霉菌和酵母菌的计数、分离、培养用。 |
| 021016 | 卵磷脂-吐温80孟加拉红培养基 | 250g/瓶 | 供霉菌和酵母菌的计数、分离、培养用。 | |
| 1.6 洋葱伯克霍尔德菌群检验 | ||||
| 试验 | 货号 | 产品名称 | 产品规格 | 用途 |
| 增菌 | 027010 | SCDLP液体培养基 | 250g | 用于疏水性化妆品样品处理及化妆品和一次性使用卫生用品中细菌的增菌培养。 |
| CP7010P2 | SCDLP液体培养基 | 90mL/瓶×40瓶 | ||
| 分离 | 022216 | 洋葱伯克霍尔德菌群 选择性琼脂培养基(BCSA) | 250g/瓶 | 用于化妆品、药品中洋葱伯克霍尔德菌的选择性分离培养。 |
| SR0680 | 洋葱伯克霍尔德菌 选择性琼脂(BCSA)配套试剂 | 10支/盒 | 供霉菌和酵母菌的计数、分离、培养用。 | |
| 纯培养 | 028074 | 胰酪大豆胨琼脂培养基 | 250g | 广泛应用于细菌的培养。 |
| 028074A | 胰酪大豆胨琼脂平板 | 90mm×20个/盒 | ||
| 过氧化氢酶试验 | 029161 | 3%过氧化氢溶液 | 10支/盒 | 用于过氧化氢酶试验。 |
| 柠檬酸盐利用 | 075200 | 西蒙氏柠檬酸盐 | 20支/盒 | 用于柠檬酸盐利用试验。 |
| 赖氨酸脱羧酶试验 | 075280 | 赖氨酸脱羧酶 | 20支/盒 | 用于赖氨酸脱羧酶试验。 |
| 075290 | 氨基酸脱羧酶对照 | 20支/盒 | ||
| 029110 | 无菌液体石蜡 | 10mL/瓶 | ||
| 1.7 培养基质量控制参比培养基 | ||||
| 货号 | 产品名称 | 产品规格 | 用途 | |
| 028074C1 | 胰蛋白胨大豆琼脂(TSA)参比培养基 | 100g | 用于食品化妆品微生物检验用培养基的质量控制。 | |
| 028074C2 | 胰蛋白胨大豆琼脂(TSA)参比培养基 | 250g | ||
| 021099C1 | 沙氏葡萄糖琼脂(SDA)参比培养基 | 100g | ||
| 021099C2 | 沙氏葡萄糖琼脂(SDA)参比培养基 | 250g | ||
| 二、化妆品防腐挑战测试系列产品
| 试验 | 货号 | 产品名称 | 产品规格 | 用途 |
| 化妆品样品稀释 | 027012 | 改良卵磷脂肉汤/改良Letheen肉汤 | 250g/瓶 | 用于化妆品微生物检验中样品的稀释。 |
| 022014 | D/E中和肉汤 | 250g/瓶 | ||
| 027013 | Eugon LT 100 肉汤 | 250g/瓶 | ||
| 027014 | TAT肉汤培养基 | 250g/瓶 | ||
| 细菌计数 | 027020 | 卵磷脂一吐温80营养琼脂 | 250g/瓶 | 用于化妆品细菌总数测定。 |
| 霉菌酵母计数 | 021010 | 孟加拉红培养基(虎红琼脂) | 250g/瓶 | 供霉菌和酵母菌的计数、分离、培养用。 |
| 细菌培养 | 028074 | 胰酪大豆胨琼脂培养基 | 250g/瓶 | 用于一般细菌保存菌种、纯培养以及需氧菌总数计数。 |
| 真菌培养 | 021099 | 沙氏葡萄糖琼脂培养基 | 250g/瓶 | 用于酵母和霉菌培养及总数计数。 |
| 细菌计数 | 027016 | Eugon LT100琼脂培养基 | 250g/瓶 | 用于化妆品中的好氧嗜温菌的检测和计数。(ISO) |
| 三、SN/T2206化妆品微生物检验系列产品
| 3.1 沙门氏菌检验 | ||||
| 试验 | 货号 | 产品名称 | 产品规格 | 用途 |
| 增菌 | 027010 | SCDLP液体培养基 | 250g/瓶 | 用于疏水性化妆品样品处理及化妆品和一次性使用卫生用品中细菌的增菌培养。 |
| CP0300 | 四硫磺酸钠煌绿增菌液(TTB) | 10mL×20支/盒 | 用于沙门氏菌的选择性增菌培养。 | |
| 023030 | 四硫磺酸钠煌绿增菌液基础(TTB) | 250g/瓶 | 临用前,每100mL (023030) 基础添加配套试剂SR0040中的碘液和煌绿各1支,配成TTB肉汤。用于沙门氏菌的选择性增菌培养。 | |
| SR0040 | 四硫磺酸钠煌绿增菌液配套试剂 | 2×5支/盒 | ||
| 平板分离 | 023052 | 亚硫酸铋琼脂 | 250g/瓶 | 用于沙门化菌的选择性分离培养。 |
| 029999 | XLD琼脂培养基 | 250g/瓶 | 用于革兰氏阴性肠杆菌特别是沙门氏菌和志贺氏菌选择性分离培养。 | |
| CP0180 | XLD琼脂培养基(平板) | 90mm×20个/盒 | ||
| 023070 | HE琼脂培养基 | 250g/瓶 | ||
| CP0110 | HE琼脂培养基(平板) | 90mm×20个/盒 | ||
| 镜检 | 029010 | 革兰氏染色液 | 10mL×4瓶 | 染色镜检。 |
| 生化鉴定 | 022080 | 三糖铁琼脂 | 250g/瓶 | 用于鉴别肠道菌发酵蔗糖、乳糖、葡萄糖及产生硫化氢的生化反应。 |
| CP0080 | 三糖铁斜面 | 20支/盒 | ||
| HKI003 | EasyID沙门氏菌生化鉴定条 | 10测试/盒 | 用于沙门氏菌的生化鉴定。 | |
| 3.2 需氧芽孢杆菌和蜡样芽孢杆菌 | ||||
| 试验 | 货号 | 产品名称 | 产品规格 | 用途 |
| 平板计数 | 028381 | 甘露醇卵黄多粘菌素琼脂平板 | 90mm×20个 | 用于蜡样芽孢杆菌的分离培养及计数。 |
| 028380 | 甘露醇卵黄多粘菌素琼脂培养基基础(MYP) | 250g | 临用前,每95mL (028380) 基础中添加配套试剂 (SR0170) 1支和50%的卵黄液5mL,制成MYP平板,用于蜡样芽孢杆菌的分离培养及计数。 | |
| SR0170 | 多粘菌素B(MYP及胰酪胨大豆多粘菌素B肉汤配套试剂) | 10支/盒 | ||
| 029250 | 50%卵黄液 | 5mL×10支/盒 | ||
| 镜检 | 029010 | 革兰氏染色液 | 10mL×4瓶 | 染色镜检。 |
| 生化确证 | 029161 | 3%过氧化氢溶液 | 10支/盒 | 用于触酶试验。 |
| 029172 | 氧化酶试剂 | 约50测试/盒 | 用于氧化酶试验。 | |
| 075010 | 葡萄糖 | 20支(西林瓶)/盒 | 用于鉴别细菌对葡萄糖的发酵反应。 | |
| 075320 | 硝酸盐(还原) | 20支(西林瓶)/盒 | 用于鉴别细菌还原硝酸盐的反应。 | |
| 071803 | 溶菌酶营养肉汤 | 20支(西林瓶)/盒 | 用于细菌耐受溶菌酶试验。 | |
| 071804 | 质控营养肉汤 | 20支(西林瓶)/盒 | ||
| 026050 | 半固体琼脂 | 250g/瓶 | 用于细菌动力观察。 | |
| C26050G1 | 半固体琼脂 | 20支/盒 | ||
| CP0800 | 胰酪胨大豆羊血琼脂平板 | 90mm×20/盒 | 用于蜡样芽孢杆菌的溶血性试验。 | |
| 028382 | L-酪氨酸营养琼脂基础 | 250g/瓶 | 用于蜡样芽孢杆菌的L-酪氨酸分解试验。 | |
| SR0580 | L-酪氨酸营养琼脂配套试剂 | 10支(西林瓶)/盒 | ||
| 029063 | 蛋白质毒素结晶体染色液 | 10mL/盒 | 用于苏云金芽孢杆菌蛋白质毒素结晶体的染色。 | |
| 3.3 肺炎克雷伯氏菌检验 | ||||
| 试验 | 货号 | 产品名称 | 产品规格 | 用途 |
| 稀释 | CP0310 | 0.85%生理盐水 | 9mL×20支/盒 | 用于样品稀释。 |
| 增菌 | 027010 | SCDLP液体培养基 | 250g/瓶 | 疏水性化妆品样品处理及化妆品和一次性使用卫生用品中细菌的增菌培养。 |
| 平板分离 | 023062 | 胆硫乳琼脂(DHL) | 250g/瓶 | 用于肠道致病菌及肺炎克雷伯氏菌的分离培养。 |
| 023065 | 胆硫乳琼脂平板 | 90mm×20个/盒 | ||
| 生化确证 | 029161 | 3%过氧化氢溶液 | 10支/盒 | 用于触酶试验。 |
| 029172 | 氧化酶试剂 | 约50测试/盒 | 用于氧化酶试验。 | |
| 022020 | 营养琼脂 | 250g/瓶 | 用于细菌总数测定,保存菌种及纯培养,也可用于消毒效果测定。 | |
| CP0150 | 营养琼脂 | 20支/盒 | ||
| 026050 | 半固体琼脂 | 250g/瓶 | 用于细菌动力观察。 | |
| C26050G1 | 半固体琼脂 | 20支/盒 | ||
| 3.4 链球菌检验 | ||||
| 试验 | 货号 | 产品名称 | 产品规格 | 用途 |
| 增菌 | 027010 | SCDLP液体培养基 | 250g/瓶 | 疏水性化妆品样品处理及化妆品和一次性使用卫生用品中细菌的增菌培养。 |
| 平板分离 | 028361 | 脑-心浸萃琼脂培养基 | 100g/瓶 | 广泛用于霉菌、酵母、细菌的培养,包括营养要求较高的微生物的培养。 |
| 024070 | 血(琼脂)平板 | 90mm×20个/盒 | 用于营养要求较高的细菌的培养及溶血试验。 | |
| 镜检 | 029010 | 革兰氏染色 | 10mL×4瓶/盒 | 染色镜检。 |
| 触酶试验 | 029161 | 3%过氧化氢溶液 | 10支/盒 | 用于触酶试验。 |
| 3.5 肠球菌检验 | ||||
| 试验 | 货号 | 产品名称 | 产品规格 | 用途 |
| 增加 | 028340 | 叠氮化物葡萄糖液态培养基 | 250g/瓶 | 用于粪链球菌及肠球菌的选择性培养。 |
| 平板分离 | 028961 | Pfizer选择性肠球菌琼脂培养基 | 100g/瓶 | 用于粪链球菌及肠球菌的分离培养。 |
| 镜检 | 029010 | 革兰氏染色 | 10mL×4瓶/盒 | 染色镜检。 |
| 触酶试验 | 029161 | 3%过氧化氢溶液 | 10支/盒 | 用于触酶试验。 |
| 3.6 破伤风梭菌检验 | ||||
| 试验 | 货号 | 产品名称 | 产品规格 | 用途 |
| 稀释 | CP0310 | 0.85%生理盐水 | 90mm×20个/盒 | 用于样品稀释。 |
| 增菌 | 027140 | 庖肉培养基基础 | 250g/瓶 | 用于厌氧菌的增菌培养,配制时需添加庖肉牛肉粒。 |
| 027150 | 庖肉牛肉粒 | 100g/瓶 | ||
| 平板分离 | 024070 | 血(琼脂)平板 | 90mm×20个/盒 | 用于营养要求较高的细菌的培养及溶血试验。 |
| 镜检 | 029010 | 革兰氏染色 | 10mL×4瓶/盒 | 染色镜检。 |
| 触酶试验 | 029161 | 3%过氧化氢溶液 | 10支/盒 | 用于触酶试验。 |
| 3.7 白色念珠菌检验 | ||||
| 试验 | 货号 | 产品名称 | 产品规格 | 用途 |
| 增菌 | 027010 | SCDLP液体培养基 | 250g/瓶 | 疏水性化妆品样品处理及化妆品和一次性使用卫生用品中细菌的增菌培养。 |
| 镜检 | 029010 | 革兰氏染色 | 10mL×4瓶/盒 | 染色镜检。 |
| 厚膜孢子试验 | 021105 | 1%吐温80玉米粉琼脂培养基 | 100g/瓶 | 用于厚膜孢子试验。 |
| SR0410 | 1%吐温80玉米粉琼脂培养基配套试剂 | 10mL/支 | ||
| 3.8 胆汁酸耐受革兰氏阴性菌检验 | ||||
| 试验 | 货号 | 产品名称 | 产品规格 | 用途 |
| 增菌 | 027010 | SCDLP液体培养基 | 250g/瓶 | 疏水性化妆品样品处理及化妆品和一次性使用卫生用品中细菌的增菌培养。 |
| 平板分离 | 022222 | 结晶紫中性红胆盐葡萄糖琼脂 | 250g/瓶 | 用于肠杆菌科细菌的分离。 |
| 3.9 铜绿假单胞菌检验 | ||||
| 试验 | 货号 | 产品名称 | 产品规格 | 用途 |
| 增菌 | 027010 | SCDLP液体培养基 | 250g/瓶 | 疏水性化妆品样品处理及化妆品和一次性使用卫生用品中细菌的增菌培养。 |
| PCR检测 | FZ001BF2 | 铜绿假单胞菌核酸检测试剂盒(PCR-荧光探针法) | 48测试/盒 | 用于铜绿假单胞菌检测。 |
| 3.10 金黄色葡萄球菌检验 | ||||
| 试验 | 货号 | 产品名称 | 产品规格 | 用途 |
| 增菌 | 027010 | SCDLP液体培养基 | 250g/瓶 | 疏水性化妆品样品处理及化妆品和一次性使用卫生用品中细菌的增菌培养。 |
| 024010 | 7.5%氯化钠肉汤 | 250g/瓶 | 用于金黄色葡萄球菌和其它耐盐菌的选择性增菌培养。 | |
| PCR检测 | FZ004BF2 | 金黄色葡萄球菌核酸快速检测试剂盒(PCR-荧光探针法) | 48测试/盒 | 用于金黄色葡萄球菌检测。 |
| 3.11 嗜麦芽窄食单胞菌检验 | ||||
| 试验 | 货号 | 产品名称 | 产品规格 | 用途 |
| 增菌 | 027010 | SCDLP液体培养基 | 250g/瓶 | 疏水性化妆品样品处理及化妆品和一次性使用卫生用品中细菌的增菌培养。 |
| 平板分离 | 024070 | 血(琼脂)平板 | 90mm×20个/盒 | 用于营养要求较高的细菌的培养及溶血试验。 |
| 纯培养 | 028050 | MH琼脂 | 250g/瓶 | 用于药敏试验琼脂稀释法及扩散法。 |
| CP0220 | MH平板 | 90mm×20个/盒 | ||
| 镜检 | 029010 | 革兰氏染色 | 10mL×4瓶/盒 | 染色镜检。 |
| 生化鉴定 | 022240 | 克氏双糖铁琼脂 | 250g/瓶 | 用于鉴别肠道菌发酵葡萄糖和乳糖,及产生硫化氢的生化反应。 |
| CP0190 | 克氏双糖铁琼脂斜面 | 20支/盒 | ||
| 026051 | SIM动力培养基 | 250g/瓶 | 用于菌株动力、靛基质、硫化氢试验。 | |
| 075660 | SIM动力培养基 | 20支(西林瓶)/盒 | ||
| 022250 | 明胶培养基 | 100g/瓶 | 用于明胶生化试验。 | |
| 075310 | 明胶 | 20支(西林瓶)/盒 | ||
| 075160 | 七叶苷 | 20支(西林瓶)/盒 | 用于七叶苷生化试验。 | |
| 075320 | 硝酸盐 | 20支(西林瓶)/盒 | 用于硝酸盐还原试验。 | |
| 029070 | 硝酸盐还原试剂 | 10mL×2瓶 | ||
| 029172 | 氧化酶试剂 | 约50测试/盒 | 用于氧化酶试验。 | |
| 029110 | 无菌液体石蜡 | 10mL/瓶 | 覆盖液体培养基,用于厌氧培养。 | |
| 3.12 洋葱伯克霍尔德菌群检验 | ||||
| 试验 | 货号 | 产品名称 | 产品规格 | 用途 |
| 增菌 | 027010 | SCDLP液体培养基(含多粘菌素B的SCDLP增菌液基础) | 250g/瓶 | 用于疏水性化妆品样品处理及化妆品和一次性使用卫生用品中细菌的增菌培养。 |
| SR0760 | SCDLP增菌液配套试剂 | 10支/盒 | 每支添加于100mLSCDLP液体培养基中。 | |
| 022217 | 含庆大霉素的BCSA增菌液 | 250g/瓶 | 用于化妆品中洋葱伯克霍尔德氏菌的选择性增菌培养。 | |
| SR0800 | BCSA增菌液配套试剂 | 10支/盒 | 每支添加于100mL含庆大霉素的BCSA增菌液基础中。 | |
| 分离 | 022216 | 洋葱伯克霍尔德菌群选择性琼脂培养基(BCSA) | 250g/瓶 | 用于化妆品、药品中洋葱伯克霍尔德菌的选择性分离培养。 |
| SR0680 | 洋葱伯克霍尔德菌选择性琼脂(BCSA)配套试剂 | 10支/盒 | 供霉菌和酵母菌的计数、分离、培养用。 | |
| 027070 | 含多粘菌素B、庆大霉素的麦康凯琼脂基础 | 250g/瓶 | 用于化妆品中洋葱伯克霍尔德菌的分离培养。 | |
| SR0780 | 含多粘菌素B、庆大霉素的麦康凯琼脂配套试剂 | 10支/盒 | 每支添加于100mL的含多粘菌素B、庆大霉素的麦康凯琼脂基础中。 | |
| 纯培养 | 028074 | 胰酪大豆胨琼脂培养基 | 250g/瓶 | 广泛应用于细菌的培养。 |
| 028074A | 胰酪大豆胨琼脂平板 | 90mm×20个/盒 | ||
| 过氧化氢酶试验 | 029161 | 3%过氧化氢溶液 | 10支/盒 | 用于过氧化氢酶试验。 |
| 氧化酶试验 | 029172 | 氧化酶试剂 | 50测试/瓶 | 用于氧化酶试验。 |
| 生化试验 | 075200 | 西蒙氏柠檬酸盐 | 20支(西林瓶)/盒 | 用于柠檬酸盐利用试验。 |
| 075370 | 葡萄糖(产气) | 20支(西林瓶)/盒 | 用于葡萄糖氧化发酵试验。 | |
| 075050 | 蔗糖 | 20支(西林瓶)/盒 | 用于蔗糖氧化试验。 | |
| 075160 | 七叶苷 | 20支(西林瓶)/盒 | 用于七叶苷利用试验。 | |
| 四、化妆品生产环境微生物监控
| 试验 | 货号 | 产品名称 | 产品规格 | 用途 |
| 浮游菌和沉降菌采样 | HKM-11 | 浮游菌采样器 | 流量:100L/分钟 尺寸:110×135×330mm 重量:2.6kg | 用于浮游菌采样。 |
| 028074 | 胰酪大豆胨琼脂培养基 | 250g/瓶 | 用于一般细菌保存菌种、纯培养以及需氧菌总数计数。 | |
| CP0201C | TSA (90mm) 平皿(三层无菌包装) | 90mm×10个/包 | 用于酵母和霉菌培养及总数计数。 | |
| 021099 | 沙氏葡萄糖琼脂培养基 | 250g/瓶 | 用于酵母和霉菌培养及总数计数。 | |
| CP0301C | SDA (90mm) 平皿(三层无菌包装) | 90mm×20个/包 | 用于医药工业洁净室沉降菌和浮游菌检测。 | |
| 表面微生物监测 | 022020 | 营养琼脂 | 250g/瓶 | 用于细菌总数测定、保存菌种及纯化用。 |
| CP0101C | NA (90mm) 平皿(三层包装) | 90mm×10个/包 | 用于细菌总数测定、保存菌种及纯化用。 | |
| CP0201J | TSA接触皿(三层包装) | 55mm×10个/包 | 用于洁净区表面微生物检测。 | |
| CP0301J | SDA接触皿(三层包装) | 55mm×10个/包 | ||
| CP0101J | NA接触皿(三层包装) | 55mm×10个/包 | ||
| HK-PS | 采集转运拭子 | 50支×6包/箱 | 培养基为生理盐水。 | |
| HK-PBS | 采集转运拭子 | 50支×6包/箱 | 培养基为磷酸盐缓冲液。 | |
| HK-BPW | 采集转运拭子 | 50支×6包/箱 | 培养基为缓冲蛋白胨水。 |

| 五、化妆品微生物检验所需菌种
| 1、Q-Strain定量菌株 | |||
| 适用检验方法 | 菌种名称编号 | 产品货号 | 规格 |
| 耐热大肠菌群检验/ 防腐挑战测试 | 大肠埃希氏菌 CMCC(B)44102 | QS012A | 110-1100 CFU/瓶 |
| QS012B | (0.6-2.0)×107 CFU/瓶 | ||
| 铜绿假单胞菌检验/ 防腐挑战测试 | 铜绿假单胞菌 CMCC(B)10104 | QS009A | 110-1100 CFU/瓶 |
| QS009B | (0.6-2.0)×107 CFU/瓶 | ||
| 金黄色葡萄球菌检验/ 防腐挑战测试 | 金黄色葡萄球菌 CMCC(B)26003 | QS007A | 110-1100 CFU/瓶 |
| QS007B | (0.6-2.0)×107 CFU/瓶 | ||
| 霉菌和酵母菌检验/ 防腐挑战测试 | 黑曲霉 CMCC(F)98003 | QS016A | 110-1100 CFU/瓶 |
| QS016B | (0.6-2.0)×107 CFU/瓶 | ||
| 白色念珠菌(白假丝酵母菌) CMCC(F)98001 | QS015A | 110-1100 CFU/瓶 | |
| QS015B | (0.6-2.0)×107 CFU/瓶 | ||
| 2、冻干质控菌种 | |||
| 适用检验方法 | 菌种名称 | 菌种编号 | 其他中心编号 |
| 菌落总数 | 大肠埃希氏菌 | FSCC149005 | CMCC(B) 44102 |
| 金黄色葡萄球菌 | FSCC223005 | CMCC(B) 26003 | |
| 枯草芽孢杆菌 | FSCC115036 | CMCC(B)63501 | |
| 耐热大肠菌群检验 | 大肠埃希氏菌 | FSCC149005 | CMCC(B) 44102 |
| 铜绿假单胞菌检验 | 铜绿假单胞菌 | FSCC206004 | CMCC(B) 10104 |
| 金黄色葡萄球菌检验 | 金黄色葡萄球菌 | FSCC223005 | CMCC(B) 26003 |
| 霉菌和酵母菌检验 | 黑曲霉 | FSCC114002 | CMCC(F) 98001 |
| 白色念珠菌 | FSCC129001 | CMCC(F) 98003 | |
| 防腐挑战测试评价 | 大肠埃希氏菌 | FSCC149005 | CMCC(B) 44102 |
| 铜绿假单胞菌 | FSCC206004 | CMCC(B) 10104 | |
| 金黄色葡萄球菌 | FSCC223005 | CMCC(B) 26003 | |
| 黑曲霉 | FSCC114002 | CMCC(F) 98003 | |
| 白色念珠菌(白假丝酵母菌) | FSCC129001 | CMCC(F) 98001 | |
